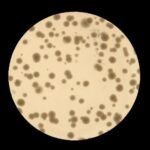
9BS
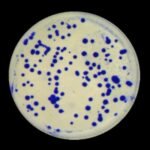
5BS

BioSpot™ solutions
Neutralization Assays and Colony Counting
Immune monitoring often requires assessing the effectiveness of serum antibodies in neutralizing viruses, bacteria, or toxins. ImmunoSpot® Readers fully support these high-throughput measurements, including colony counting across various well formats — from 384-well plates to Petri dishes.
Learn more about leveraging ImmunoSpot® Readers for high-throughput neutralization assays.

Here’s an overview of viral assays quantified by ImmunoSpot® Readers:
Viral titer
Plaque Reduction Neutralization Assay (PRNT)
Virus/serum neutralization
Viral immune-colorimetric assay (ICA)
Focus forming assay
Intracellular inclusion assay
Plaque Forming Unit / Focus-Forming Unit (PFU/FFU) assay
Cytopathic Effect (CPE)
For examples of ImmunoSpot® Readers used in SARS-CoV-2 assays, follow this link.
For a multi-color reference applying ImmunoSpot® Readers in viral studies, see J. Immunol., 2015, 195: 3490.
ImmunoSpot® Readers also excel in high-throughput bacterial colony counting across formats — from 384-well plates to Petri dishes and square agar slabs.
Commonly supported assays include:
Serum Bactericidal Assays (SBA)
Opsono-Phagocytotic Assays (OPK)
For a key bacterial colony counting reference, see J. Immunol. Methods, 2004, 292: 187.
They are also highly effective for high-throughput yeast colony counting in formats ranging from 384-well plates to Petri dishes. Applications include:
Humanized yeast models
Proteomics (Y2H)
Antibiotic testing
Toxicology
For a reference in this context, see Cell Death & Disease, 2011, 2:188.
High throughput is critical in colony counting. Optimized ImmunoSpot® Readers can count a 384-well plate in under a minute — processing up to 400 plates in a single run.
